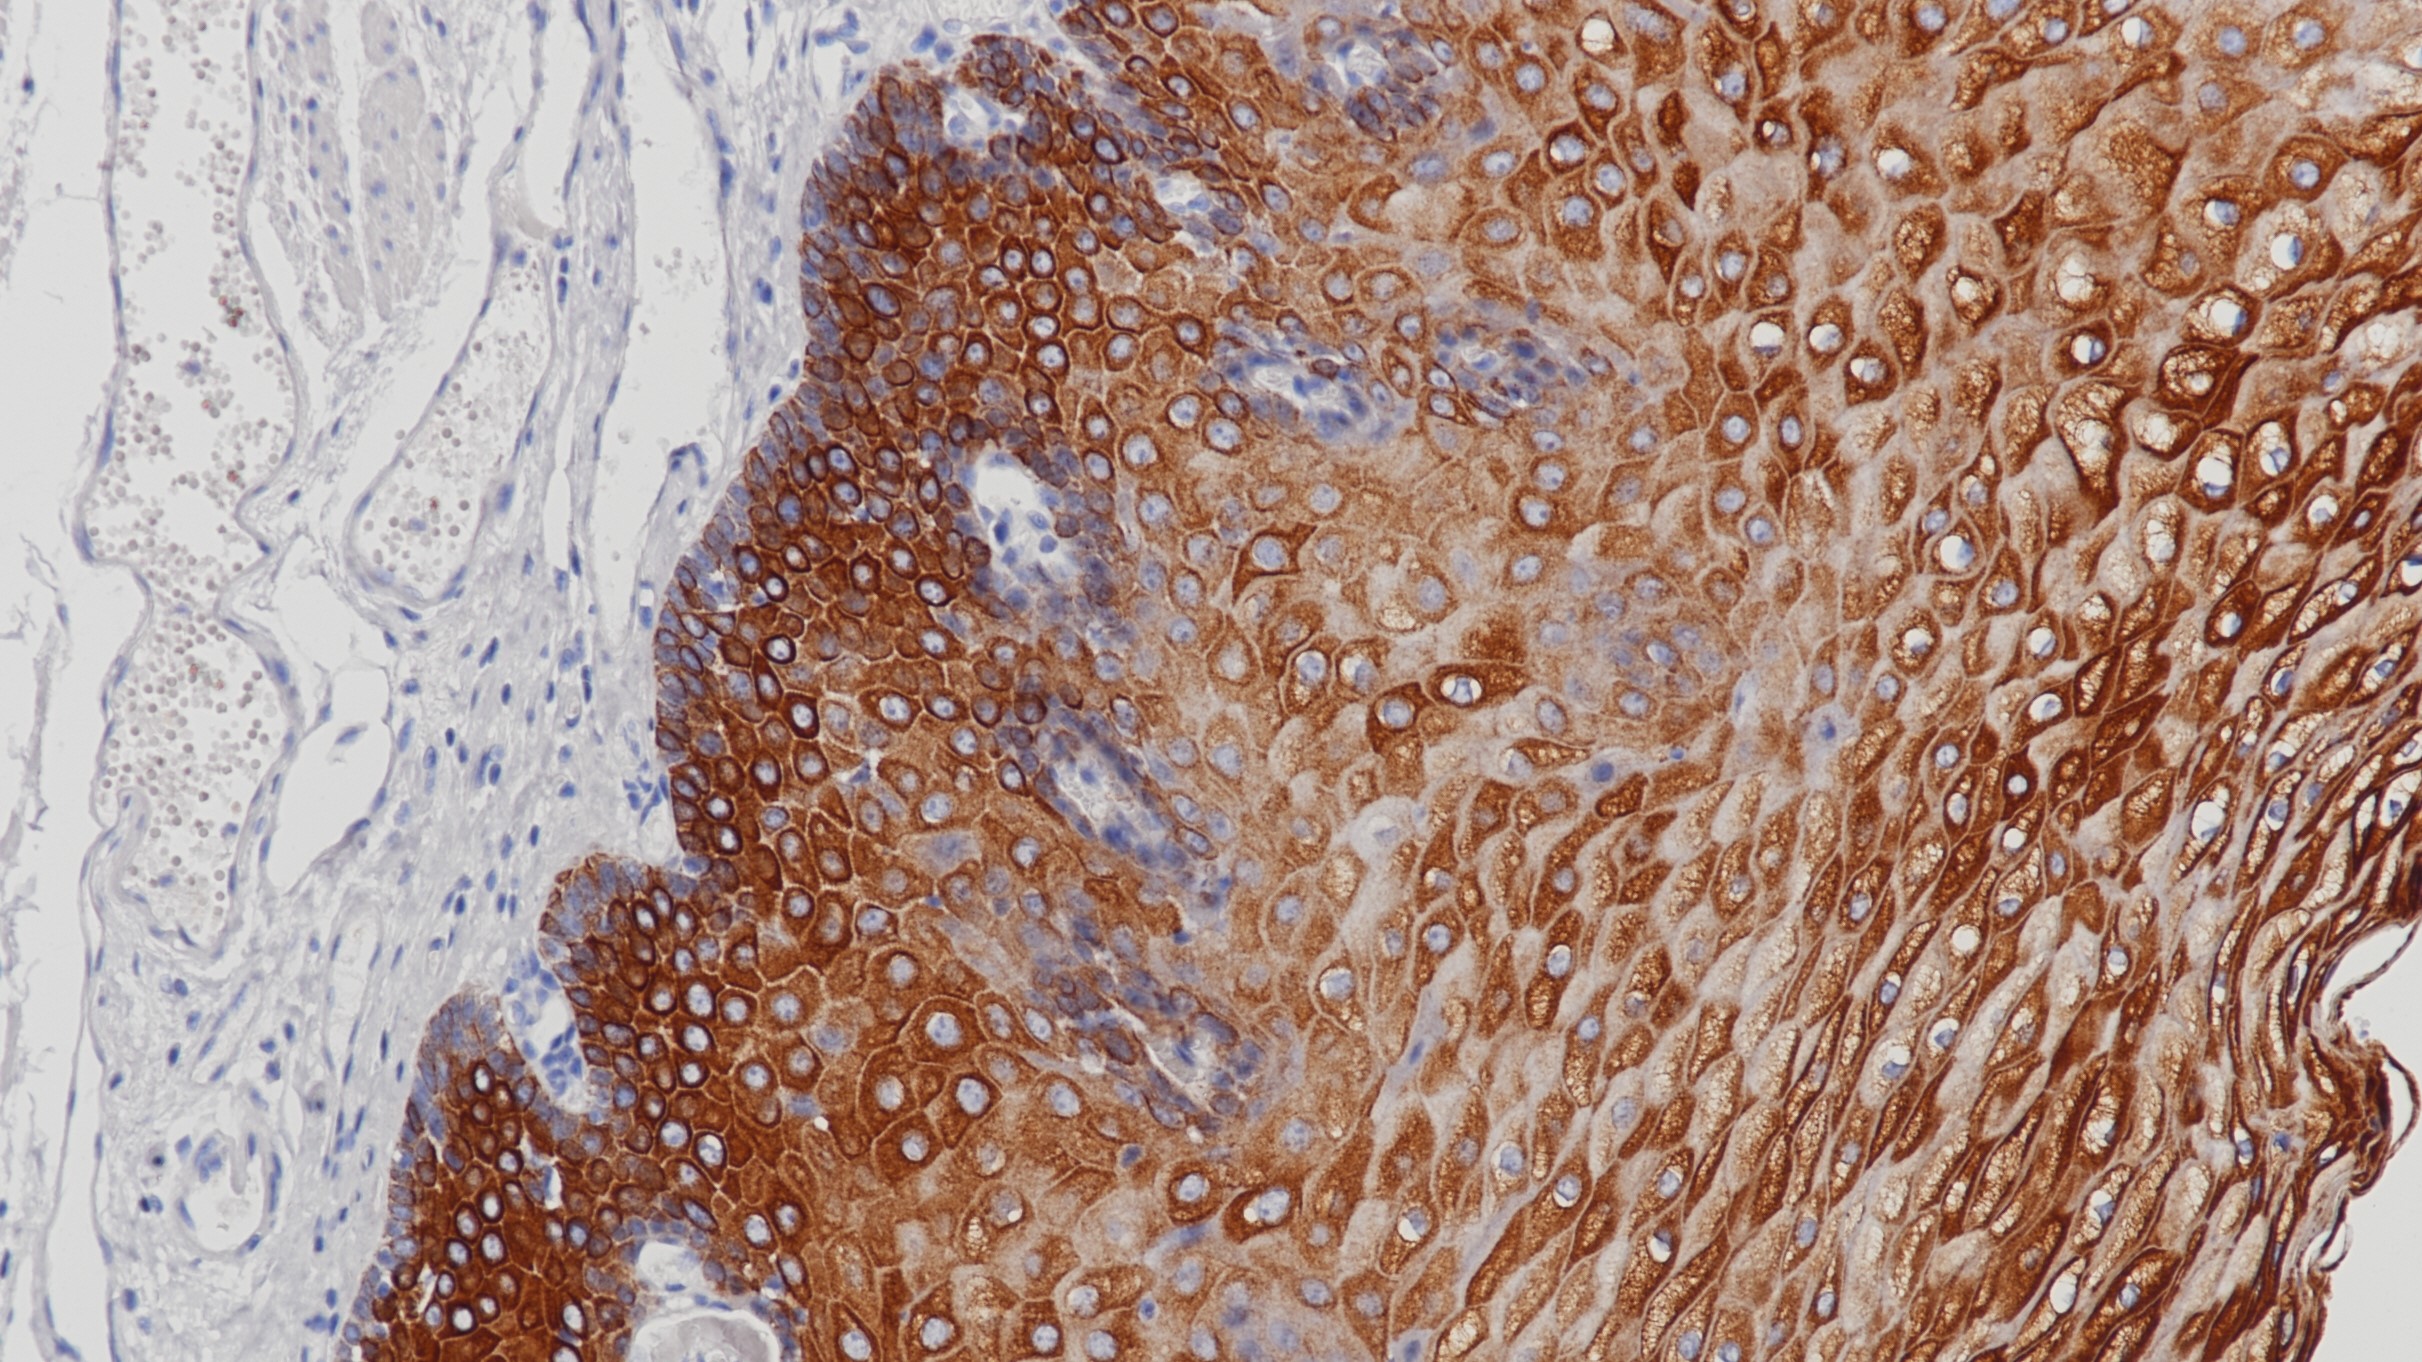
食道CK(HMW)(BP6021&BP6077)染色

1.Kriho UK, et al. Keratin expression in astrocytomas: An immunofluorescent and biochemical reassessment. Virehows Arch. 1997; 431:139-47.
2.D Oh, RA Prayson. Evaluation of epithelial and keratin markers in glioblastoma multiforme: An immunohistochemical study. Arch Pathol Lab Med—Vol 123, October 1999:917-920.